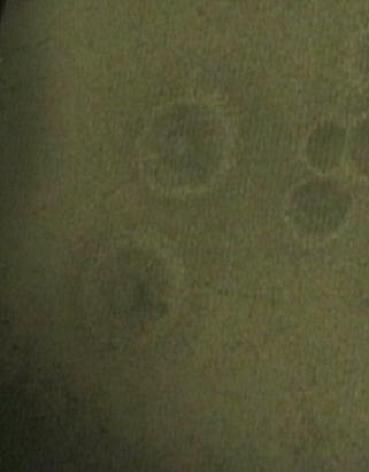

|  |
An unmistakable similarities to note are the tendrils which extend beyond the rims of the circular areas in both the CRT experiment and the image from Mars. The image below also shares those features. It was created during a burst of electric energy to an energized crt screen. Many similar patterns point to the mars feature being a micro burst of macro proportion.
Material streamed from my finger to these tendrils. |  |
Backyard Experimenter2 Image Thumbs Album Home Poster presentation 07